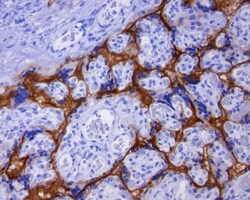

TA591003S
antibody from Invitrogen Antibodies
Targeting: CD274
B7-H, B7-H1, B7H1, PD-L1, PDCD1LG1, PDL1
Antibody data
- Antibody Data
- Antigen structure
- References [0]
- Comments [0]
- Validations
- Immunohistochemistry [3]
Submit
Validation data
Reference
Comment
Report error
- Product number
- TA591003S - Provider product page

- Provider
- Invitrogen Antibodies
- Product name
- PD-L1 Recombinant Rabbit Monoclonal Antibody (OR-5H8), TrueRAB™
- Antibody type
- Monoclonal
- Antigen
- Synthetic peptide
- Reactivity
- Human
- Host
- Rabbit
- Isotype
- IgG
- Antibody clone number
- OR-5H8
- Vial size
- 30 µL
- Concentration
- 0.5-1 mg/mL
- Storage
- -20° C, Avoid Freeze/Thaw Cycles
No comments: Submit comment
Supportive validation
- Submitted by
- Invitrogen Antibodies (provider)
- Main image
- Experimental details
- Immunohistochemical staining of FFPE human placenta with Rb monoclonal PD-L1 C/N TA591003 clone OR-5H8 at 1:100. Rb anti-PD-L1 clone OR-5H8 requires heat-induced epitope retrieval (HIER) at 120°C for 3min with ACCEL (EDTA-Tris pH8.7). Detection was done with Polink2 polymer detection system and visualized with DAB. Strong membrane staining seen in trophoblasts.
- Submitted by
- Invitrogen Antibodies (provider)
- Main image

- Experimental details
- Immunohistochemical staining of FFPE human melanoma with Rb monoclonal PD-L1 C/N TA591003 clone OR-5H8 at 1:100. Rb anti-PD-L1 clone OR-5H8requires heat-induced epitope retrieval (HIER) at 120°C for 3min with ACCEL (EDTA-Tris pH8.7). Detection was done with Polink2 polymer detection system and visualized with DAB. Strong membrane staining seen in tumor cells.
- Submitted by
- Invitrogen Antibodies (provider)
- Main image

- Experimental details
- Immunohistochemical staining of FFPE human lung cancer case 1 with Rb monoclonal PD-L1 C/N TA591003 clone OR-5H8 at 1:100. Rb anti-PD-L1 clone OR-5H8 requires heat-induced epitope retrieval (HIER) at 120°C for 3min with ACCEL (EDTA-Tris pH8.7). Detection was done with Polink2 polymer detection system and visualized with DAB. Strong membrane staining seen in tumor cells.